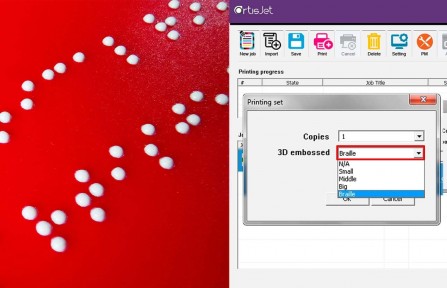

ArtisJet 3000U PRO
artis 3000U PRO
Priama tlač na všetky podklady, tmavé i priehľadné materiály.
Perfektne sa hodí pre tlač na pevné ako aj na flexibilné podklady (drevo, kov, silikón, guma atď.) Tlač na plasty s vysokým rozlíšením je možný vďaka antistatickému modulu.
.jpg) Pozrite si video ►
Pozrite si video ►
 3D efekt tlače
3D efekt tlače
Živá reprodukcia farieb a kreativity na rôzne materiály ( akrylové / sklo / drevo / hliníkové značenie stien, značenie na dvere a kancelárie, tabuľky, ocenenia, atď..) Artisjet UV LED tlačiareň je vhodná pre potlač rôznych darčekových a reklamných predmetov. Je ideálnym pomocníkom pre 3D efekt tlače ako i pre špeciálny druh písma - Braillovo písmo.
Ľahká obsluha
UV tlačiareň Artisjet 3000U PRO je vynovená verzia UV tlačiarne 3000U, má plne automatické nastavovanie výšky vďaka bočným senzorom, až do výšky 17cm.
Poskytuje komfortnú obsluhu s jedinečným prevedením bočného ukladania predmetov na potlač. Jednoduché riadenie úloh a výkonné funkcie Vám uľahčia prácu, kde jedným kliknutím nastavíte počet kópií, výsledky tlače a RIP.

Rotačné zariadenie pre potlač valcovitých predmetov
Veľkou výhodou je voliteľná možnosť rozšíriť tlačiareň o rotačné zariadenie pre potlač valcovitých predmetov ako poháre, fľaše, sviečky a rôzne iné.
 |
 |
 |
Okrem potlače na valcovité, okrúhle predmety sa dá tlačiareň doplniť o funkciu "Varnish printing", s ktorým môžete dosiahnuť vysoko lesklý povrch tlače.
Poskytuje optimálne náklady s úplne novými kazetami CISS. Stolová tlačiareň s profesionálnym čistením vzduchu, ideálny pre malé aj veľké pracovné prostredie. Disponuje s funkciou "automatické opakovanie", zabezpečuje jednoduchú a bezpečnú prevádzku.
Technická špecifikácia| Rýchlosť tlače | veľkosť A4 @ 2880x1440 dpi: | |
| Unidirection - 460 sekúnd | ||
| Bidirection - 245 seconds | ||
| Technológia tlače | UV LED | |
| Atrament | artisink DTS3 kazety | |
| (CMYK+WWWW / CMYK+WW+V V) | ||
| Materiál | Aplikácia tlače | puzdrá, kryty, darčekové a reklamné predmety, perá, USB kľúče, menovky, trofeje, PVC karty, zapaľovače, menšie kufre, pod. |
| Rozmer tlače | B3+, 360x500mm | |
| Hrúbka materiálu | až do 170mm | |
| Tlač | Režimy tlače | 4 pass |
| 8 pass | ||
| 16 pass | ||
| Rozlíšenie tlače | až do 2880x1440 dpi | |
| Tlačová hlava | Epson DX7 | |
| Trisky | technológia variabilnej veľkosti kvapky od 1,5 pl až do 21 pl | |
| Pripojenie | Porty | USB 2.0 |
| Operačný systém | Windows | |
| Rozmery | HxŠxV | Tlačiareň 940x840x540mm |
| Balenie1040x1040x720mm | ||
| Váha | Tlačiareň 120kg, Balenie 146kg | |
| Obsah balenia | artis 3000U PRO, USB kábel, napájací kábel, CD s ovládačmi, čipy na kazety, RIP software | |
| Teplota prostredia | 10-35°C | |
| Spotreba energie | ~75W, vstupné napätie | |
| Požiadavky na napájanie | 110V/220V 50-60HZ | |
| Certifikáty | CE / FCC / RoHS / REACH certifikované | |
| Záruka | 1 rok limitovaná záruka |